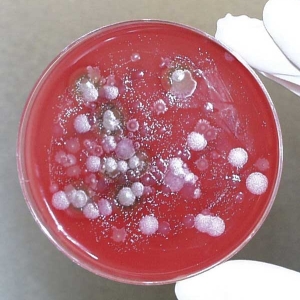
Биологические агенты

Акридонуксусная кислота
Акридонуксусная кислота (10-карбоксиметил-9-акридон) — органическое соединение, низкомолекулярный индуктор интерферона, оказывает противовирусное, иммуностимулирующее, противовоспалительное действия. Основной активный компонент для изготовления лекарственных препаратов «Циклоферон», «Неовир», «Камедон». Брутто-формула: C15H11NO3. Молекулярная масса: 253,25 г/моль.